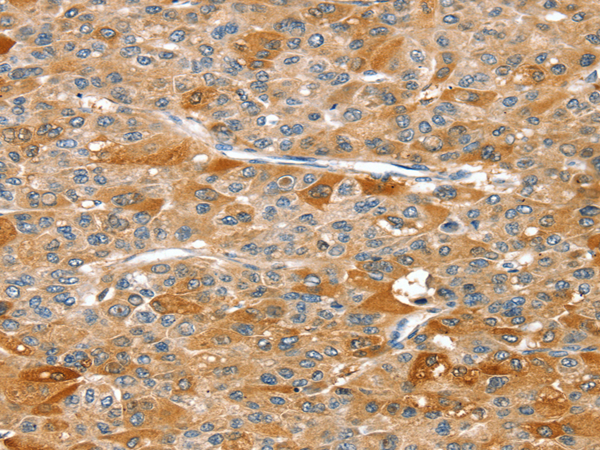

|
Background: |
This gene encodes a dual serine/threonine and tyrosine protein kinase which is expressed in multiple tissues. It is thought to function as a regulator of cell death. Multiple transcript variants encoding different isoforms have been found for this gene. |
|
Applications: |
ELISA, WB, IHC |
|
Name of antibody: |
DSTYK |
|
Immunogen: |
Fusion protein of human DSTYK |
|
Full name: |
dual serine/threonine and tyrosine protein kinase |
|
Synonyms: |
RIP5; RIPK5; CAKUT1; DustyPK; HDCMD38P |
|
SwissProt: |
Q6XUX3 |
|
ELISA Recommended dilution: |
1000-2000 |
|
IHC positive control: |
Human liver cancer |
|
IHC Recommend dilution: |
25-100 |
|
WB Predicted band size: |
105 kDa |
|
WB Positive control: |
823 and hepg2 cells |
|
WB Recommended dilution: |
200-1000 |

購物車
購物車 幫助
幫助
 021-54845833/15800441009
021-54845833/15800441009
